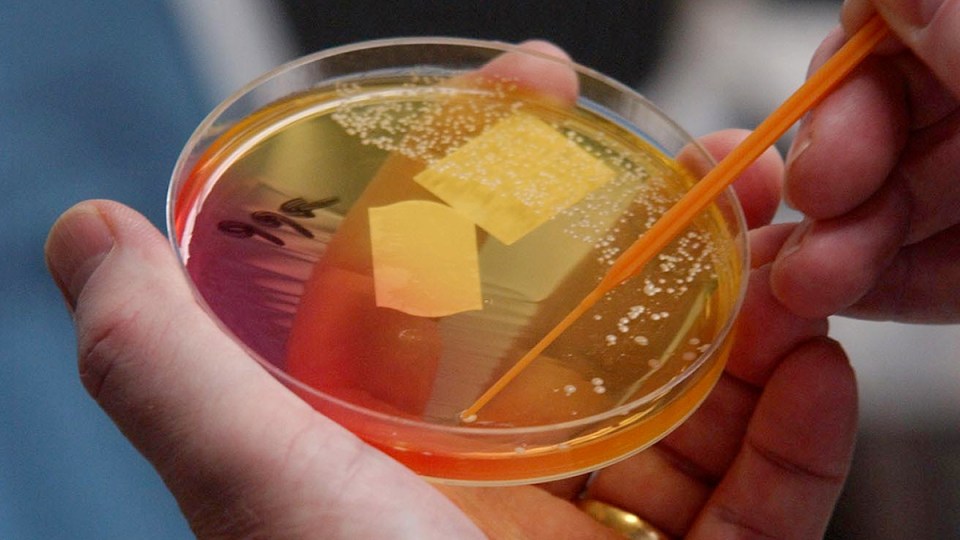
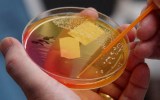

A new light therapy can kill off some of the worst antibiotic-resistant superbugs in what South Australian researchers say will be a game changer for millions worldwide.
The therapy, developed by the University of South Australia, has been found to significantly eradicate golden staph and pseudomonas aeruginosa superbugs, among the most deadly.
“Golden staph and pseudomonas aeruginosa are both highly transmissible bacteria, commonly found on people’s skin. But if they get into the blood, they can lead to sepsis or even death,” lead researcher Muhammed Awad said.
“Patients in hospitals – particularly those with wounds or catheters, or those on ventilators – have a higher risk of getting these bacteria and, while antibiotics may help, their extensive use has led to waves of microbial resistance, often making them ineffective.
Tweet from @ClivePrestidge
“Our photodynamic technology works differently, harnessing the energy of light to generate highly reactive oxygen molecules that eradicate microbial cells and kill deadly bacteria, without harming human cells.”
Researcher Clive Prestidge said the technology had key advantages over conventional antibiotics and other light therapies.
“The new therapy is created in an oil that is painted on a wound as a lotion,” he said.
“When laser light is applied to the lotion, it creates reactive oxygen species which act as an alternative to conventional antibiotics.”
Professor Prestidge said current photoactive compounds suffered from poor water solubility, which meant that they had limited clinical application.
“Our approach uses food-grade lipids to construct nanocarriers for the photoactive compound which improves its solubility and antibacterial efficiency far beyond that of an unformulated compound,” he said.
“These molecules target multiple bacterial cells at once, preventing bacteria from adapting and becoming resistant. So, it’s a far more effective and robust treatment.
“Importantly, the human skin cells involved in the wound healing process showed enhanced viability, while the antibiotic-resistant bacteria were entirely eradicated.”
Antibiotic-resistant superbugs cost millions of lives around the world each year with a significant impact on the global economy.
Researchers said the next step was commercial trials to develop the therapy.
-AAP